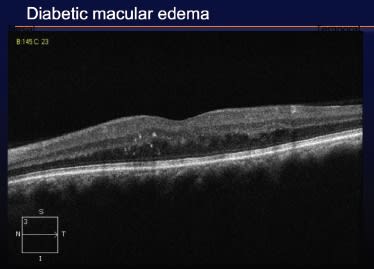

Applying HD-OCT to Diabetic Retinopathy
Recognition of distinct diabetic macular edema patterns may aid in tailoring treatment strategies.

By Peter K. Kaiser, MD
In the past, the diagnosis of diabetic macular edema (DME) was based solely on clinical examination, ie, careful binocular slit lamp biomicroscopy. The definition of clinically significant macular edema (CSME) derived from the Early Treatment Diabetic Retinopathy Study depends only on clinical exam findings, the location of hard exudates and retinal thickening in relation to the fovea. Today, however, we also use fluorescein angiography and SD-OCT to help us manage our patients with DME. In this article, I explain why the latter is an increasingly important part of my practice.
Uses and Limitations of Fluorescein Angiography
For me, fluorescein angiography serves two main purposes in the diagnosis and management of DME. I use it to confirm the diagnosis at baseline. I also use it to evaluate the amount of ischemia and to guide laser treatment. (It is not yet possible to evaluate ischemia with OCT, although that may change with future Doppler technologies.)
On the other hand, angiography has limitations when it comes to DME. First, the degree of leakage on FA does not correlate with visual acuity or clinical outcomes. Furthermore, it does not provide information about vitreoretinal abnormalities.
Macular Thickness Mapping and Change Analysis
In contrast to FA, the macular thickness maps generated by OCT correlate very well with other key features of DME. Increased thickening on the maps corresponds to clinical leakage, fluorescein leakage and decreased vision.1-3 As retinal thickness increases, visual acuity worsens.
The Macular Change Analysis algorithm utilized by the Cirrus HD-OCT instrument, which allows us to automatically evaluate changes at the same location in the retina from one patient visit to the next, is also advantageous in DME (Figure 1). It provides an efficient and effective way to track disease progression and evaluate treatment efficacy, just as it does when we are following patients with age-related macular degeneration. I like to show my patients the Macular Change Analysis difference maps, as well, to illustrate for them how they are doing.

Figure 1. The Macular Change Analysis capability of the Cirrus HD-OCT is an efficient and effective way to track progression of diabetic macular edema and evaluate treatment efficacy.
Identifying DME Patterns for Better Treatment Choices
As useful as thickness maps and change analysis are in following patients with DME, they do not reveal structural details or information about vitreomacular interactions. In this regard, the Cirrus line scan tomograms, B-scans and 3-D views are particularly beneficial. The B-scans demonstrate several distinct patterns that can be associated with DME. It is important to recognize the various patterns because they impact prognoses and may require different treatment strategies.
In the most common pattern of DME, termed the sponge-like pattern (Figure 2), we start to see an increase in retinal thickness. Usually, there are no cysts in the outer retina. Fluid absorption causes the inner layers of the retina to look compressed. This pattern may be minimal in terms of macular edema; therefore, it may not be visible clinically. In the future, we will need to decide whether to treat patients with sponge-like DME before they meet ETDRS criteria. We certainly see it first on SD-OCT.
Figure 2. In the sponge-like DME pattern, fluid absorption makes the inner retinal layers appear compressed.
The increased thickening involved with sponge-like DME correlates very well with visual acuity. The thicker the retina, the worse the visual acuity. Eyes exhibiting this pattern respond extremely well to laser treatment.
Diabetic cystoid macular edema (Figure 3) is seen in about half of patients with DME. These patients' eyes have more leakage, leading to the development of cysts. Over time, the cysts begin to coalesce. As they coalesce, the foveal depression diminishes, creating a volcano-like appearance. This pattern is associated with worse visual acuity than the sponge-like pattern. In fact, when multifocal electroretinograms are performed in the setting of diabetic CME, the response is reduced more than the sponge-like pattern.

Figure 3. The diabetic cystoid macular edema pattern, shown on SD-OCT, is associated with worse visual acuity than the sponge-like pattern.
In my experience, eyes with diabetic CME respond better to treatment with anti-vascular endothelial growth factor drugs and steroids than they do to laser.
Serous Retinal Detachment With No Posterior Hyaloid Traction
Another pattern we see in association with DME is serous retinal detachment with no posterior hyaloid traction (Figure 4). In these cases, the greatest subretinal fluid accumulation is usually in the fovea. In general, the fluid is not evident on ophthalmoscopy. The hallmark of this pattern is that any fluid evident on SD-OCT is due to only fluid, not traction. Fluid resorption often leads to deposition of hard exudates within the subretinal space. This pattern generally does not respond to laser treatment.

Figure 4. After a steroid was used to treat this serous retinal detachment with no posterior hyaloid traction in an eye with DME, the amount of fluid and the retinal thickness decreased. Visual acuity also improved.
The Cirrus HD-OCT is very helpful for detecting epiretinal phenomena. If they are not visible, they are not there. That is different than with the Stratus OCT, where not seeing them did not necessarily mean they were not present.
Diabetic Macular Edema Due to Posterior Hyaloid Traction
We used to think DME due to posterior hyaloid traction occurred in approximately 16% of patients. We have since learned there are really two subgroups of posterior hyaloid traction patients. One group, first described by Hilel Lewis, is distinct in that these patients have a grayish sheen to the retina on clinical exam. They have traction that is causing their edema leading to a tent-like appearance on SD-OCT. The retina is actually being pulled up into a traction detachment. The 3-D capabilities of HD-OCT provide excellent visualization of this pattern (Figure 5). At this time, it appears vitrectomy and peeling of the traction may be the most effective strategy for improving macular edema and visual acuity in these cases.

Figure 5. In cases where SD-OCT shows DME caused by posterior hyaloid traction, peeling of the traction may be the most effective strategy for improving macular edema and visual acuity.
Unfortunately, most cases of DME due to hyaloid traction are not in the anterior-posterior direction. They are due to tangential traction (Figure 6). The best way to treat these patients has yet to be determined. Should we perform surgery for tangential traction? Should we be using anti- VEGF injections? At this time, we do not know. The Diabetic Retinopathy Clinical Research Network is conducting a study to determine if removing the tangential traction would be beneficial.

Figure 6. The appropriate treatment for DME resulting from tangential traction, rather than anterior-posterior hyaloid traction, has yet to be determined.
SD-OCT's Role in Proliferative Disease
SD-OCT also can be useful for diagnosis and management of patients with proliferative diabetic eye disease. For example, it is helpful for evaluating vitreous traction. In addition, it can help to determine if traction is affecting the macula in cases where it is not obvious. SD-OCT clearly provides higher-quality images in these situations than Stratus OCT.
Multiple Uses in Diabetic Care
SD-OCT has become an important tool for me as I provide care for patients with diabetic eye disease, DME in particular. I use it to evaluate morphologic patterns to make more precise treatment decisions, help educate patients about the status of their conditions and monitor response to treatment.
Dr. Kaiser is professor of ophthalmology at the Cleveland Clinic Lerner College of Medicine and founding director of the Cole Eye Institute's Digital OCT Reading Center (DOCTR).
REFERENCES
1. Strom C, Sander B, Larsen N, Larsen M, Lund-Andersen H. Diabetic macular edema assessed with optical coherence tomography and stereo fundus photography. Invest Ophthalmol Vis Sci 2002;43:241-245.
2. Hee MR, Puliafito CA, Duker JS, et al. Topography of diabetic macular edema with optical coherence tomography. Ophthalmology 1998;105:360-370.
3. Browning DJ. Potential pitfalls from variable optical coherence tomograph displays in managing diabetic macular edema. Am J Ophthalmol 2003;136:555-557.








